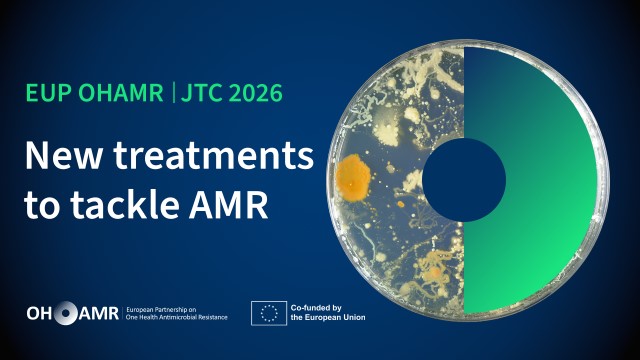

Aktualności
Aktualności
-

Ogłoszenie XXV edycji konkursu o Grant Naukowej Fundacji Polpharmy
NABÓR TRWA do 29.05.2026
27.04.2026
Biuro Projektów informuje o ogłoszeniu XXV edycji konkursu o Grant Naukowej Fundacji Polpharmy
-

Ogłoszenie o naborze w konkursie NAWA "Wspólne projekty badawcze"
NABÓR TRWA do 30.06.2026
15.04.2026
Biuro Projektów informuje, że Narodowa Agencja Wymiany Akademickiej ogłosiła nabory w programie Wspólne projekty badawcze pomiędzy:
-

Ogłoszenie o naborze w ramach programu „AGROSTRATEG”
NABÓR TRWA od 28.08.2026
02.04.2026
Biuro Projektów informuje o ogłoszeniu przez Dyrektora Narodowego Centrum Badań i Rozwoju I konkursu w ramach programu „AGROSTRATEG”
-

Ogłoszenie konkursów OPUS 31 i PRELUDIUM 25
NABÓR TRWA do 16.06.2026
16.03.2026
Biuro Projektów informuje o ogłoszeniu przez Narodowe Centrum Nauki kolejnych edycji konkursów OPUS i PRELUDIUM.
-

Ogłoszenie o naborze wniosków w konkursie Ścieżka SMART dla konsorcjów
NABÓR TRWA do 12.06.2026
10.03.2026
Biuro Projektów informuje o ogłoszonym przez Narodowe Centrum Badań i Rozwoju konkursie Ścieżka SMART Projekty realizowane w konsorcjach w ramach programu Fundusze Europejskie dla Nowoczesnej Gospodarki na innowacyjne projekty badawczo-rozwojowe, których powodzenie wymaga współpracy biznesu, nauki, a także organizacji pozarządowych.
-

Ogłoszenie konkursu MINIATURA 10
NABÓR TRWA do 31.07.2026
03.02.2026
Biuro Projektów informuje o ogłoszeniu przez Narodowe Centrum Nauki kolejnej edycji konkursu MINIATURA.
-

Zapowiedź konkursu LUKE Joint Call na międzynarodowe projekty badawcze realizowane we współpracy z zespołami z Ukrainy.
NABÓR ZAKOŃCZONY
21.01.2026
Biuro Projektów informuje, że 27 lutego 2026 r. zostanie ogłoszony konkurs w ramach partnerstwa LUKE Joint Call mający na celu wsparcie projektów badawczych realizowanych w ramach współpracy międzynarodowej, z Ukrainą jako kluczowym partnerem.
-

Ogłoszenie o naborze do projektu ZBADAI – przedsięwzięcie edukacyjne
NABÓR ZAKOŃCZONY
02.04.2026
Biuro Projektów zachęca naukowców i naukowczynie z różnych dyscyplin naukowych do wspólnego udziału w projekcie ZBADAI – przedsięwzięciu edukacyjnym realizowanym przez Centrum Nauki Kopernik we współpracy z Ministerstwem Edukacji Narodowej.
-

Ogłoszenie o naborze do 26. edycji programu L'Oréal-UNESCO Dla Kobiet i Nauki
NABÓR ZAKOŃCZONY
05.03.2026
Biuro Projektów zachęca studentki, doktorantki i pracownice UMLUB do udziału w 26. edycji programu L'Oréal-UNESCO Dla Kobiet i Nauki
-

Ogłoszenie o naborze zgłoszeń do projektu „Nauka ma głos”
NABÓR ZAKOŃCZONY
05.02.2026
Biuro Projektów zachęca do przesyłania zgłoszeń do projektu „Nauka ma głos”.
-

Ogłoszenie o naborze wniosków w ramach I edycji konkursu w Programie LIDER UP
NABÓR ZAKOŃCZONY
28.01.2026
Biuro Projektów informuje o ogłoszeniu przez Dyrektora Narodowego Centrum Badań i Rozwoju I edycji konkursu w Programie LIDER UP.
-

Ogłoszenie o planowanym naborze wniosków Proof of Concept FENG
NABÓR ZAKOŃCZONY
23.01.2026
Biuro Projektów informuje o planowanym naborze wniosków w działaniu Proof of Concept (PoC FENG).
-

Wydłużenie terminu naboru wewnętrznego do dnia 31.01.2026 r.: Partnerstwa Strategiczne NAWA – nabór 2025.
NABÓR ZAKOŃCZONY
16.12.2025
Biuro Projektów informuje o ogłoszeniu konkursu Partnerstwa Strategiczne NAWA – nabór 2025.
-

Ogłoszenie konkursu SONATINA 10
NABÓR ZAKOŃCZONY
16.12.2025
Biuro Projektów informuje o ogłoszeniu przez Narodowe Centrum Nauki kolejnej edycji konkursu SONATINA.
-

Nabór wniosków w ramach programu „Fulbright Specialist Program’’
NABÓR ZAKOŃCZONY
05.12.2025
Biuro Projektów informuje o trwającym naborze wniosków w ramach programu Fulbright Specialist Program - krótkoterminowej wymiany naukowo-badawczej w celu pogłębienia oraz rozszerzenia współpracy między polskimi instytucjami a amerykańskimi naukowcami i naukowczyniami.
-

Nabór wniosków o udział w programie TOP200 im. Weigla
NABÓR ZAKOŃCZONY
05.12.2025
Biuro Projektów informuje o naborze wniosków o udział w programie TOP200 im. Weigla ogłoszonym przez Narodową Agencję Wymiany Akademickiej.
-

Konkurs w ramach Partnerstwa HE, European Partnership for Personalised Medicine (EP PerMed)
NABÓR ZAKOŃCZONY
27.11.2025
Biuro Projektów informuje o ogłoszeniu konkursu w ramach Partnerstwa HE, European Partnership for Personalised Medicine (EP PerMed) na finansowanie międzynarodowych projektów badawczych dotyczących zdrowia.
-
Konkurs na międzynarodowe, interdyscyplinarne projekty badawcze pn. Treatments and adherence to treatment protocols (OH-TREAT)
19.11.2025
Biuro Projektów informuje, że Narodowe Centrum Nauki we współpracy z Europejskim Partnerstwem One Health Antimicrobial Resistance (OH AMR) ogłosiło konkurs na międzynarodowe, interdyscyplinarne projekty badawcze pn. Treatments and adherence to treatment protocols (OH-TREAT), których celem jest opracowanie nowych innowacyjnych metod leczenia antybiotykooporności.
-

ERA4Health - konkurs JTC 2026 PREVENT-OO
17.11.2025
Biuro Projektów informuje o ogłoszeniu konkursu w ramach partnerstwa ERA4Health pt. Understanding and Preventing Overweight and Obesity (PREVENT-OO) na finansowanie międzynarodowych projektów badawczo-rozwojowych.
-

Nabór wniosków do konkursu „Społeczna odpowiedzialność nauki III’’
NABÓR ZAKOŃCZONY
08.10.2025
Biuro Projektów informuje o naborze wniosków w ramach kolejnej edycji programu „Społeczna odpowiedzialność nauki III”
-

Nabór wniosków do konkursu "Nauka dla Rozwoju Społeczeństwa”
NABÓR ZAKOŃCZONY
08.10.2025
Biuro Projektów informuje o otwarciu naboru wniosków do programu Ministra Nauki i Szkolnictwa Wyższego pn. „Nauka dla Rozwoju Społeczeństwa”.
-

Ogłoszenie konkursu SONATA 21
NABÓR ZAKOŃCZONY
30.09.2025
Biuro Projektów informuje, że Narodowe Centrum Nauki ogłosiło kolejną edycję konkursu na realizację projektu badawczego SONATA 21.
-

Ogłoszenie konkursu OPUS 30 z międzynarodową ścieżką LAP
NABÓR ZAKOŃCZONY
30.09.2025
Biuro Projektów informuje, że Narodowe Centrum Nauki ogłosiło kolejną edycję konkursu na realizację projektu badawczego OPUS 30 z międzynarodową ścieżką LAP.
-

Nabór do VI edycji Konkursu „Lublin Akademicki”
NABÓR ZAKOŃCZONY
30.09.2025
Biuro Projektów informuje o planowanym naborze wniosków do VI edycji Konkursu „Lublin Akademicki”, którego celem jest wspieranie potencjału akademickiego miasta.
-

Nabór do V edycji Konkursu „Visiting Professors in Lublin”
NABÓR ZAKOŃCZONY
30.09.2025
Biuro Projektów informuje o ogłoszonej przez Prezydenta Miasta Lublin V edycji Konkursu „Visiting Professors in Lublin”.
